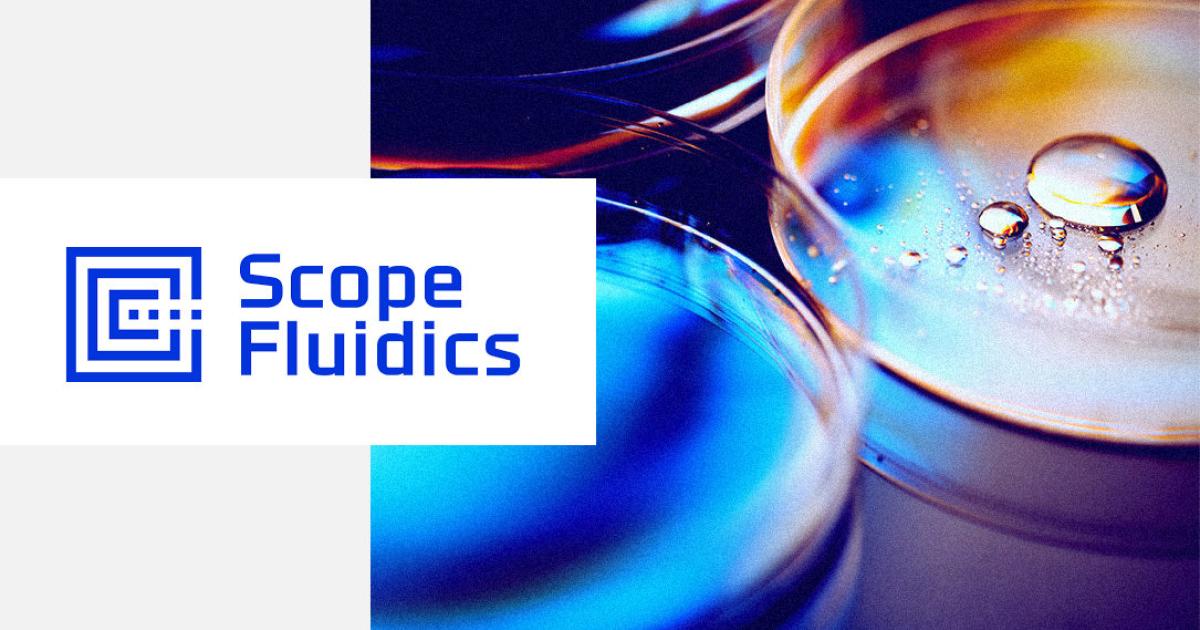

Scope Fluidics z ambicjami na prestiżowy grant z programu Horyzont 2020
Bacteromic – spółka wchodząca w skład Grupy Kapitałowej Scope Fluidics S.A. – prowadzi starania o dofinansowanie projektu BacterOMIC w ramach 2 Fazy europejskiego programu SME Instrument. Grant ten jest częścią prestiżowego programu dotacji z Brukseli, Horyzont 2020. Jego maksymalna wysokość wynosi 2,5 mln euro.
SME Instrument jest z programem finansowania z Brukseli o bardzo wysokiej skali konkurencyjności, w którym współzawodniczy się z firmami z całej Europy. Statystycznie jedynie 4-5 proc. złożonych projektów pozyskuje dofinansowanie. BacterOMIC jest na etapie przygotowania pierwszych aplikacji. W roku 2019 będą jeszcze trzy możliwości aplikowania o tegoroczną pulę, co jest o tyle istotne, gdyż uzyskanie grantu za pierwszym podejściem jest naprawdę bardzo wyjątkową sytuacją. W procesie sporządzania materiałów niezbędnych do uzyskania grantu, Bacteromic będzie współpracował z renomowanymi ekspertami.
Faza 2 programu SME Instrument przeznaczona jest dla projektów na zaawansowanym poziomie rozwoju. Otrzymanie środków finansowych ma pomóc w dopracowaniu produktu, tak żeby był gotowy do wprowadzenia na rynek oraz w przygotowaniu do komercjalizacji. W Fazie 2 SME Instrumentu maksymalna wysokość dofinansowania projektów wynosi 2,5 mln euro. Dokładna wysokość grantu, o który wystąpi Bacteromic sp. z o.o. będzie określona w ramach szczegółowych prac nad wnioskiem o przyznanie dofinansowania.
- Zgodnie z dotychczasowymi komunikatami uruchomiamy starania o kolejne unijne dofinansowanie projektu BacterOMIC. Potencjalne pozyskanie tego grantu niesie ze sobą wiele korzyści. W przypadku pozyskania dofinansowania, poza czynnikiem – finansowym – będzie dla nas również bardzo cennym doświadczeniem na arenie międzynarodowej. Wierzymy, że prestiż związany z tym programem z pewnością pomógłby w nawiązaniu licznych kontaktów biznesowych. Dzięki temu moglibyśmy mieć szansę na szybszą komercjalizację naszego projektu. Sam system BacterOMIC ma być receptą na antybiotykoporność, i według nas ma wiele przewag by zaistnieć na globalnym rynku diagnostyki medycznej. Świadczyć o tym może m.in. otrzymana niedawno ocena Europejskiego Urzędu Patentowego – komentuje Szymon Ruta, Członek Zarządu Scope Fluidics S.A. Dyrektor Finansowy.
W drugiej połowie lutego Scope Fluidics poinformowało o otrzymaniu w ramach procedury patentowej od Europejskiego Urzędu Patentowego (EUP) „sprawozdania z poszukiwania europejskiego” i pisemnej opinii dla pierwszego europejskiego zgłoszenia patentowego dot. służącego do kompleksowego badania antybiotykoodporności bakterii systemu BacterOMIC. Urząd uznał zgłoszone rozwiązanie za nowe i odkrywcze. Oznacza to, że Spółka zakończyła z sukcesem najważniejszy etap procedury patentowej, która powinna potrwać do stycznia 2020 r.
Walka z opornością bakterii na działanie antybiotyków staje się coraz poważniejszym wyzwaniem. Już dziś w Europie 70 proc. zakażeń jest oporna na co najmniej jeden antybiotyk. Według szacunków Światowej Organizacji Zdrowia (WHO) lekooporne bakterie w ciągu najbliższych 35 lat mogą doprowadzić na świecie do śmierci nawet 300 milionów ludzi, co sprawia, że są one najważniejszym zagrożeniem dla zdrowie publicznego.
Projekt BacterOMIC, o dofinansowanie którego ubiega się Spółka, ma stanowić odpowiedź na rosnące zjawisko antybiotykooporności bakterii. Produkt Spółki ma przyspieszyć i zwiększyć skuteczność leczenia pacjentów, poprzez wskazywanie najlepszych dla danego pacjenta terapii celowanych. W ciągu kilku godzin precyzyjnie oceni wrażliwość bakterii na wszystkie klinicznie ważne antybiotyki i dostarczy lekarzowi obszernych informacji na temat danego patogenu. System BacterOMIC będzie wykorzystywał klasyczne mikrobiologiczne metody wykonywania testów antybiotykowrażliwości, w połączeniu z innowacyjną technologią mikroprzepływową. Główną przewagą konkurencyjną BacterOMICa będzie znacznie większa kompleksowość badania niż w innych systemach dostępnych na rynku. Co więcej, projekt ten ma szansę być pierwszym automatycznym systemem diagnostycznym umożliwiającym badanie kombinacji antybiotyków w przypadkach najtrudniejszych zakażeń, w których żadne antybiotyki administrowane pojedynczo, nie są skuteczne.
O spółce: Scope Fluidics jest inkubatorem start-upów technologicznych. Zajmuje się rozwojem innowacyjnych projektów w obszarze diagnostyki i ochrony zdrowia.
Firma Scope Fluidics powstała w 2010 r. w Instytucie Chemii Fizycznej Polskiej Akademii Nauk z myślą
o tworzeniu rozwiązań dla medycyny na bazie technologii mikroprzepływowych. Spółka współpracuje ze środowiskiem akademickim, łącząc punkt widzenia medycyny i przemysłu, tworząc oryginalne rozwiązania
z wysokim potencjałem komercyjnym.
Źródło: Spółka, #SCP